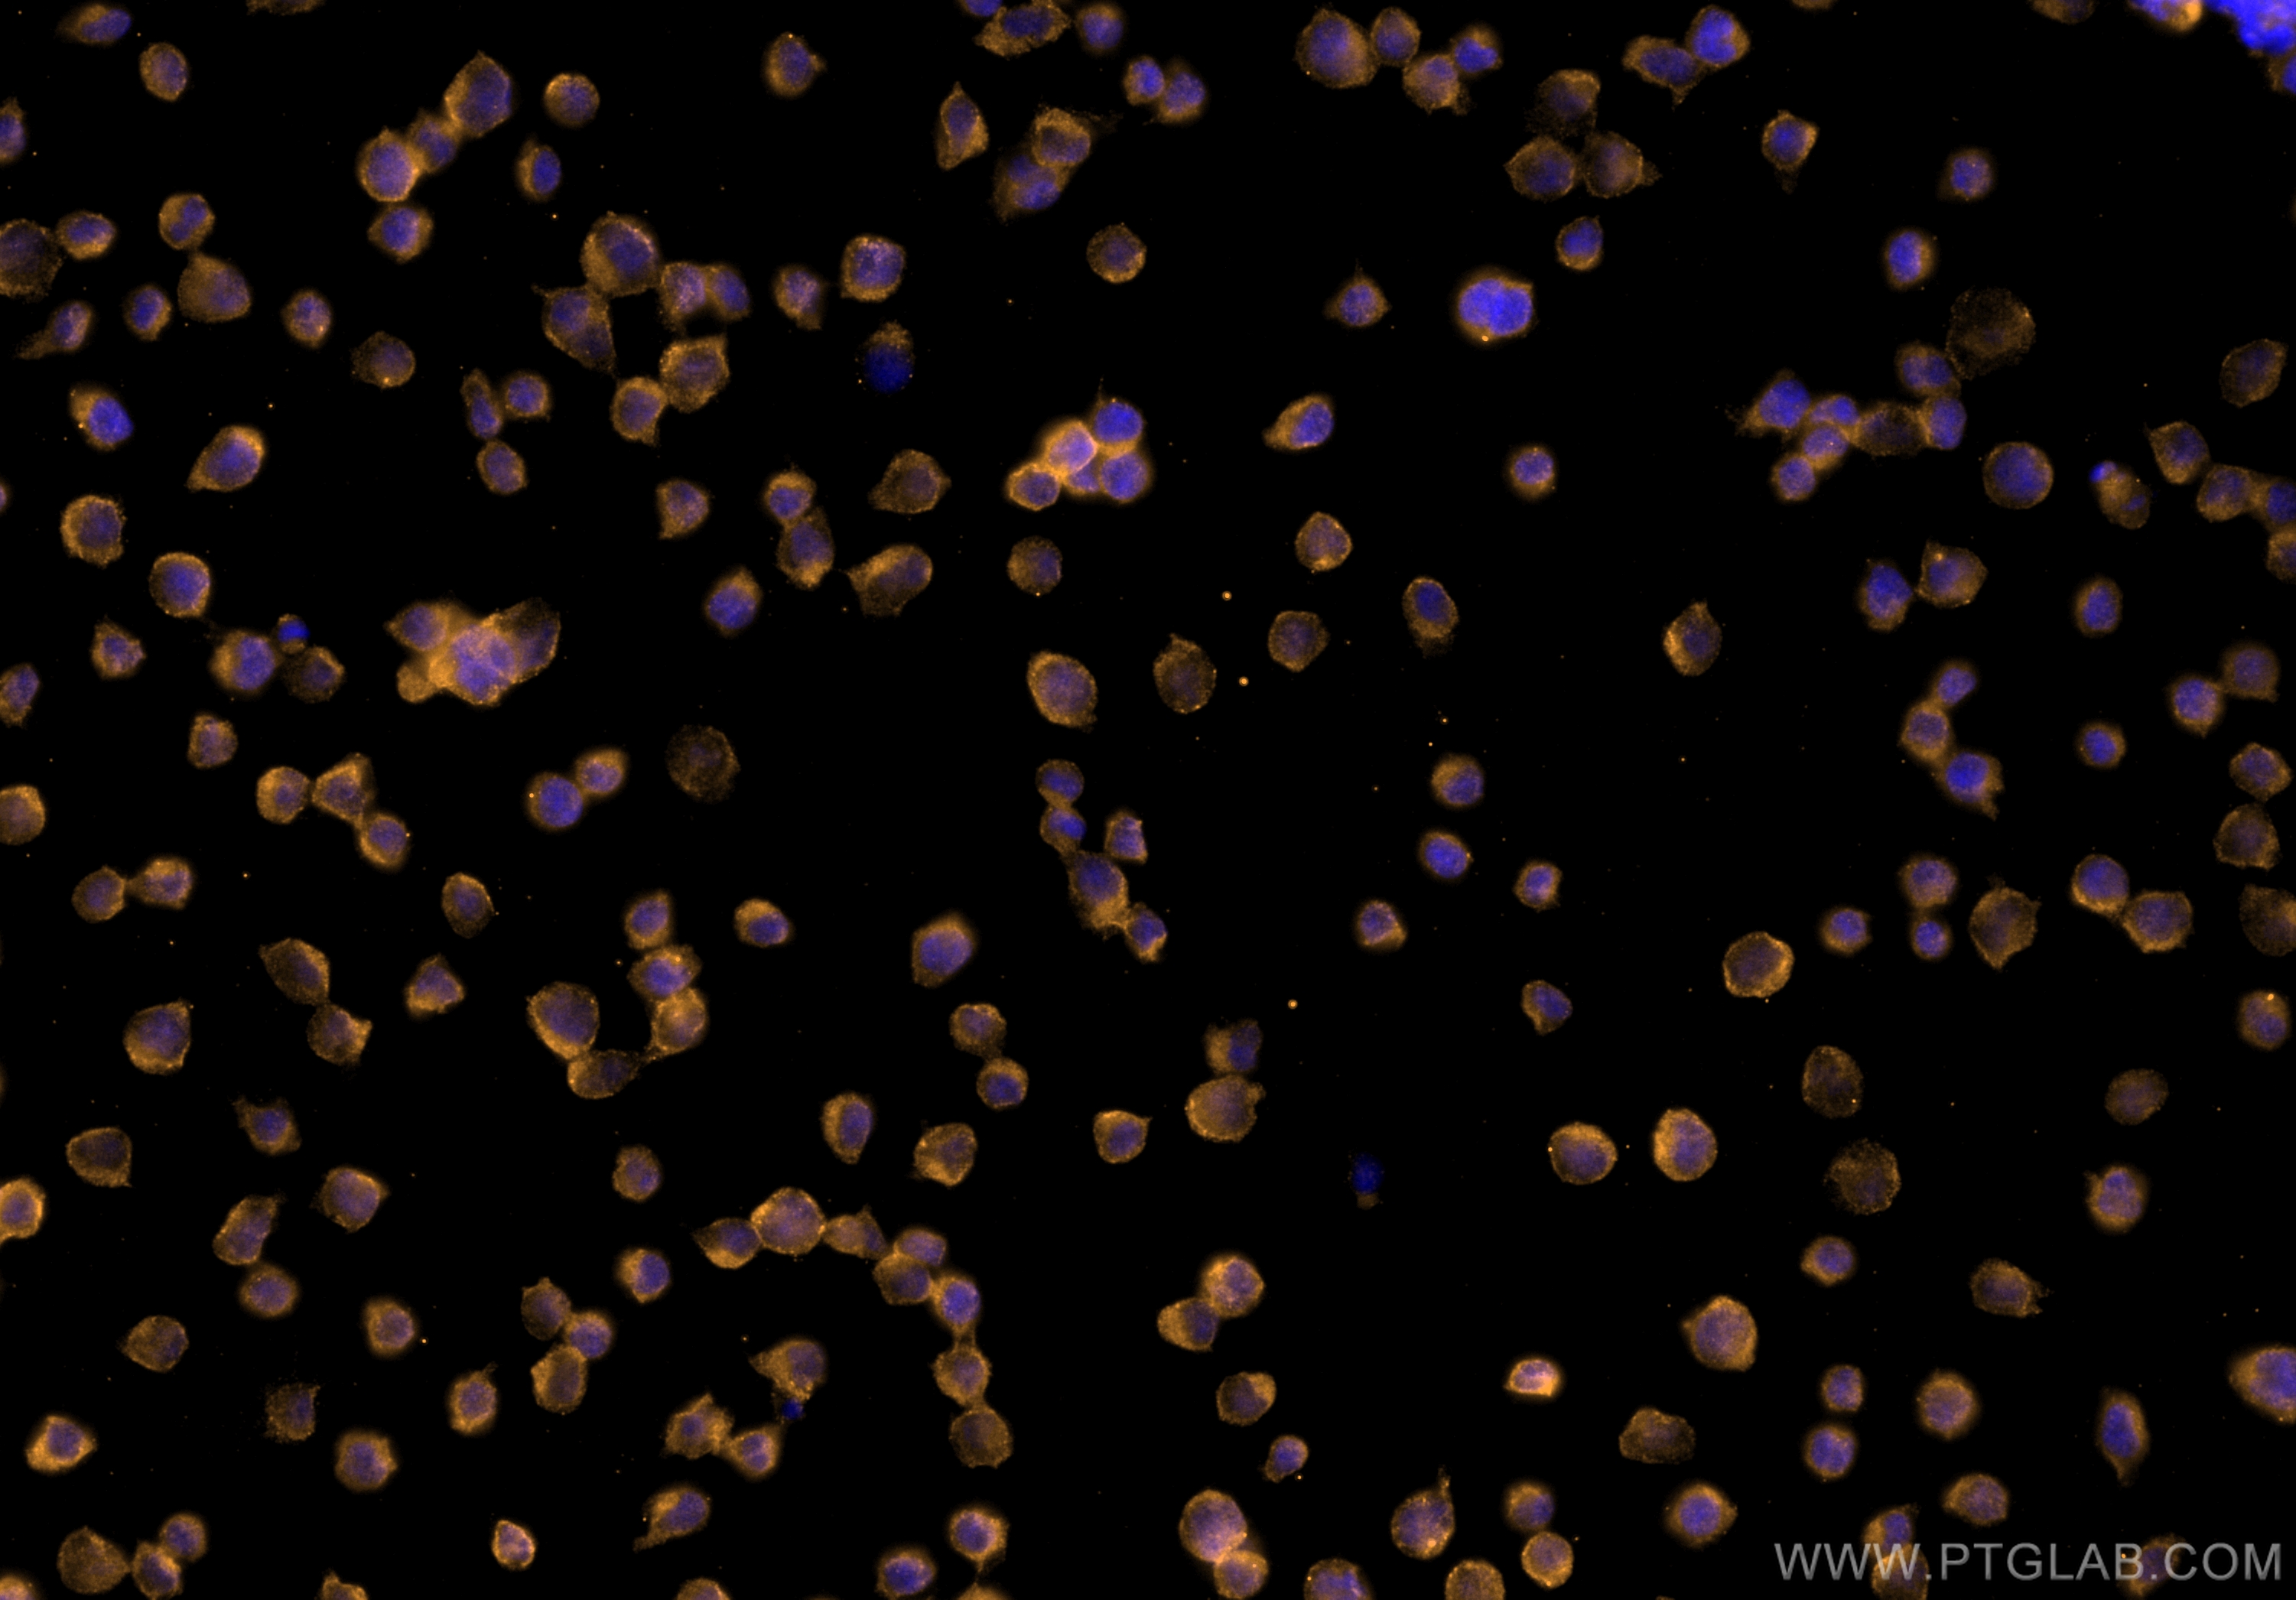

验证数据展示
经过测试的应用
| Positive IF-P detected in | mouse spleen tissue |
| Positive IF/ICC detected in | Jurkat cells |
推荐稀释比
| 应用 | 推荐稀释比 |
|---|---|
| Immunofluorescence (IF)-P | IF-P : 1:50-1:500 |
| Immunofluorescence (IF)/ICC | IF/ICC : 1:50-1:500 |
| It is recommended that this reagent should be titrated in each testing system to obtain optimal results. | |
| Sample-dependent, Check data in validation data gallery. | |
产品信息
CL555-60287 targets CD45 in IF/ICC, IF-P applications and shows reactivity with human, mouse, rat, pig samples.
| 经测试应用 | IF/ICC, IF-P Application Description |
| 经测试反应性 | human, mouse, rat, pig |
| 免疫原 |
CatNo: Ag13712 Product name: Recombinant human CD45 protein Source: e coli.-derived, PGEX-4T Tag: GST Domain: 550-750 aa of BC014239 Sequence: KIYDLHKKRSCNLDEQQELVERDDEKQLMNVEPIHADILLETYKRKIADEGRLFLAEFQSIPRVFSKFPIKEARKPFNQNKNRYVDILPYDYNRVELSEINGDAGSNYINASYIDGFKEPRKYIAAQGPRDETVDDFWRMIWEQKATVIVMVTRCEEGNRNKCAEYWPSMEEGTRAFGDVVVKINQHKRCPDYIIQKLNIV 种属同源性预测 |
| 宿主/亚型 | Mouse / IgG2a |
| 抗体类别 | Monoclonal |
| 产品类型 | Antibody |
| 全称 | protein tyrosine phosphatase, receptor type, C |
| 别名 | 4E9B2, EC:3.1.3.48, GP180, L CA, LCA |
| 计算分子量 | 1304 aa, 147 kDa |
| 观测分子量 | 220 kDa |
| GenBank蛋白编号 | BC014239 |
| 基因名称 | CD45 |
| Gene ID (NCBI) | 5788 |
| ENSEMBL Gene ID | ENSG00000081237 |
| RRID | AB_2923894 |
| 偶联类型 | CoraLite®555 Fluorescent Dye |
| 最大激发/发射波长 | 557 nm / 570nm |
| 形式 | Liquid |
| 纯化方式 | Protein A purification |
| UNIPROT ID | P08575 |
| 储存缓冲液 | PBS with 50% glycerol, 0.05% Proclin300, 0.5% BSA, pH 7.3. |
| 储存条件 | Store at -20°C. Avoid exposure to light. Stable for one year after shipment. Aliquoting is unnecessary for -20oC storage. |
背景介绍
Protein tyrosine phosphatase receptor type C (PTPRC) is also known as CD45 antigen, which was originally called leukocyte common antigen (LCA). CD45 is an enzyme required for T-cell activation through the antigen receptor consisting of two intracellular phosphatase domains, a transmembrane domain and an extracellular domain. Upon T-cell activation, CD45 recruits and dephosphorylates SKAP1 via an interaction through the first PTPase domain, which is the only domain to possess intrinsic kinase activity. However, both domains are required for appropriate phosphatase and T-cell antigen receptor activity (PMID: 8076596).
What is the molecular weight of CD45?
The molecular weight of CD45 is a 180-240 kDa.
What are the isoforms of CD45?
Six different human isoforms of CD45 have been isolated, containing all three exons (ABC isoform), two of the three exons (AB and BC isoforms), only one exon (A isoform or B isoform), or no exons (O isoform). All of the isoforms have the same eight amino acids at their amino-terminus (PMID: 12412720).
What is the tissue specificity of CD45?
CD45 is a tyrosine phosphatase expressed on the plasma membrane of all hematopoietic cells, except erythrocytes and platelets (PMID: 7803253).
What are the post-translational modifications of CD45?
CD45 can be heavily N- and O-glycosylated (PMID: 1702721).
What is CD45's involvement in disease?
Defects in CD45 are a cause of severe combined immunodeficiency autosomal recessive T-cell-negative/B-cell-positive/NK-cell-positive (T(-)B(+)NK(+) SCID); a severe form of SCID. It is classed by the impairment of both humoral and cell-mediated immunity, leukopenia, and the low or absent levels of antibodies (PMID: 10700239). Also, genetic variants of CD45 have a role in susceptibility to multiple sclerosis (PMID: 12864992).
实验方案
| Product Specific Protocols | |
|---|---|
| IF protocol for CL555 CD45 antibody CL555-60287 | Download protocol |
| Standard Protocols | |
|---|---|
| Click here to view our Standard Protocols |